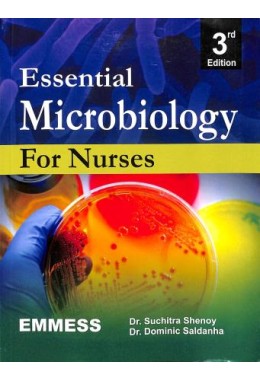
Suchitra Shenoy

0 sales
Suchitra Shenoy
Rs.550.00
Product Code: Suchitra Shenoy
Availability: In Stock

Suchitra Shenoy
Product Code: Suchitra Shenoy
Availability: In Stock

Suchitra Shenoy